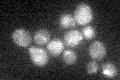
YOR037W

View description
Mitochondrial peripheral inner membrane protein, contains a FAD cofactor in a domain exposed in the intermembrane space; exhibits redox activity in vitro; likely participates in ligation of heme to acytochromes c and c1 (Cyc1p and Cyt1p)
Localization:
Intensity:
Fold change:
Significance:
-
C’ GFP library in SD
mitochondria16.07 -
N' NOP1pr-GFP in SD

mitochondria68.0407 -
N' TEF2pr-mCherry in SD

missing0 -
N' NATIVEpr-GFP in SD

below threshold21.6066 -
N' TEF2pr-VC and Cyto-VN in SD

#N/A0 -
C’ GFP library in SD+DTT

mitochondria18.971.18No -
C’ GFP library in SD+H2O2

mitochondria15.730.97No -
C’ GFP library in Starvation Media

mitochondria18.251.13No -
C’ GFP library on the background of Pup2-DaMP

mitochondria -
C’ GFP library on the background of CCT mutant

mitochondria16.07390.999862No
